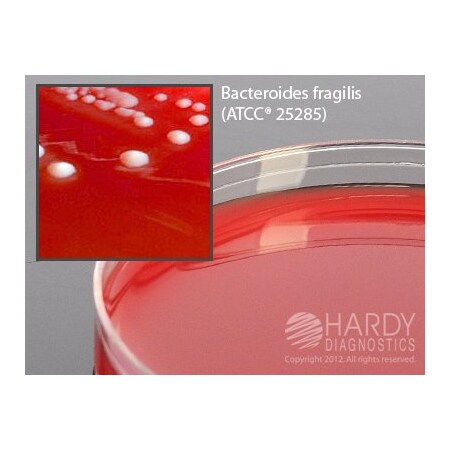
thumb

Hardy Diagnostics H05
- mpnH05
- brandname: Hardy Diagnostics
- manufacturername: Hardy Diagnostics
Brucella Agar with Hemin and Vitamin K, Large 15x150mm Plate, Order by the Package of 10, by Hardy Diagnostics


- Brand: Hardy Diagnostics
- PartNumber: H05
- Manufacturer: Hardy Diagnostics
- Label: Hardy Diagnostics